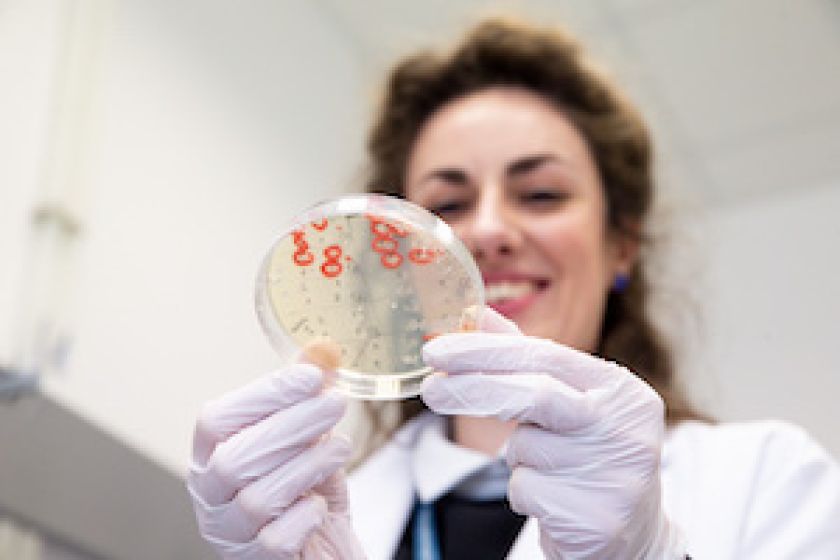

ES investicijos paspartino bendrovės „Caszyme“ mokslinių tyrimų eigą, Cas baltymų duomenų bazės išplėtimą ir padidino įmonės konkurencingumą rinkoje. Lietuvių startuolio siūlomi sprendimai padeda verslams pasirinkti optimalius genų redagavimo technologijos panaudojimo būdus. „Genų žirklės“ jau taikomos daugelyje tyrimų sričių, tarp kurių medicinoje, genetinių bei onkologinių ligų gydymui, bei žemės ūkyje – išvedant augalų rūšis atsparias ligoms, kenkėjams ir klimato kaitos poveikiui.
„CRISPR-Cas sistemų pagrindu vystome genomo redagavimo įrankius – „Genų žirkles“. Tai kryptingas DNR sekos modifikavimo metodas, iš pagrindų pakeitęs visą genų inžinerijos sritį. Iki šiol ilgi, brangūs ir sudėtingi procesai dėl naujų įrankių sukūrimo tapo pigesni, greitesni ir tikslesni. Padedame bendrovėms taikyti genų redagavimo sprendimus savo veikloje ir taip sumažinti mokslinių tyrimų ir eksperimentinės plėtros (MTEP) kaštus bei rizikas, padidinti jų verslo sėkmės tikimybę“, – sako Karolina Makovskytė, „Caszyme“ verslo vystymo vadybininkė.
Technologija pritaikoma plačiai
„CRISPR-Cas genomo redagavimo technologija jau efektyviai taikoma farmacijos, chemijos pramonėse, gaminant molekulinius reagentus ir vystant biotechnologijų mokslo sritį. Medicinoje šiuo metu vykdoma net keletas klinikinių tyrimų, kurių pagrindu kuriamos terapijos genetinėms bei onkologinėms ligoms gydyti“, – sako K. Makovskytė.
Cas baltymų pritaikymo galimybės nuolat plečiamos. Pavyzdžiui, klimato kaitos kontekste ši technologija tapo itin aktualia žemės ūkio srityje.
„Ji pasitelkiama siekiant padidinti augalų atsparumą įvairioms ligoms ir kenkėjams. Taip pat šios technologijos pagrindu išvedamos augalų veislės atsparesnės sparčiai besikeičiančioms klimato sąlygoms. Tai padeda sulaukti gausesnio derliaus ir užauginti didesnę maistinę vertę turinčius augalus“, – sako K. Makovskytė.
Pasak jos, ateityje naujų molekulinių įrankių kūrimas ir jau esamų tobulinimas ne tik atvers naujas galimybes paspartinti įvairius tyrimus daugelyje sričių, bet ir taps pagrindu naujam mokslo proveržiui.
Investicija paspartino projekto įgyvendinimą
„Pateikę projekto paraišką, sulaukėme finansavimo moksliniams tyrimams atlikti ir papildyti savo duomenų bazę naujas savybes turinčiais Cas baltymais. Tai leido pagreitinti mūsų turimos duomenų bazės plėtimą ir padidinti įmonės konkurencingumą rinkoje“, – sako K. Makovskytė.
CRISPR-Cas genomo redagavimo technologijoje naudojamų įrankių paieška ir vystymas yra labai svarbi „Caszyme“ veiklos dalis.
„Spalio mėnesį pabaigę įgyvendinti numatytas projekto veiklas toliau aktyviai komercializuojame projekto metu sukurtus sprendimus ir sustoti nežadame. Tam, kad atlieptume rinkos poreikius ir pasaulines technologijos vystymo tendencijas, planuojame ir toliau plėsti savo bendrovės siūlomas paslaugas, pildyti molekulinių genomo redagavimo įrankių duomenų bazę“, – sako K. Makovskytė.
ES priemonės „Eksperimentas“ projekto vykdymui Inovacijų agentūra (tuo metu – Lietuvos verslo paramos agentūra) UAB „Caszyme“ skyrė 200 tūkst. Eur finansavimą. Bendras bendrovės vykdyto projekto biudžetas – arti 300 tūkst. eurų. Trečdalį šios sumos investavo pati bendrovė.
Nuoseklios investicijos į inovacijas
2014 – 2020 m. finansavimo periodu į įmonių mokslinius tyrimus ir eksperimentinę plėtrą jau investuota daugiau nei 310 mln. Eur, pabaigtas 251 projektas, 236 – dar įgyvendinami. Pabaigus programą viso bus sukurta 864 inovatyvių produktų prototipai.
„Siekiame toliau skatinti inovacijų kūrimą, todėl dar praėjusią savaitę paskelbėme kvietimą „InoStartas“. Jo pagrindinės veiklos sudarys sąlygas tyrėjams dalyvauti įmonių MTEP projektuose, naujų sukurtų produktų bandomąją gamybą ir parengimą rinkai. Taip pat jau kitų metų pradžioje planuojame paskelbti dar du kvietimus: „InoPažanga“ ir „InoBranda“, skirtus MTEP inovacijoms diegti“, – sako Agnė Vaitkūnienė, Inovacijų agentūros Investicijų valdymo departamento direktorė.
Kvietimai „InoStartas“, „InoPažanga“ ir „InoBranda“ yra dalis 2022–2030 m. ekonomikos transformacijos ir konkurencingumo plėtros programos, valdomos Lietuvos Respublikos ekonomikos ir inovacijų ministerijos. Projekto veiklos finansuojamos iš ES fondų investicijų lėšų.
Visi kvietimai skelbiami Inovacijų agentūros finansavimo priemonių puslapyje.
Pranešimą paskelbė: Jolita Mažeikiėnė, Inovacijų agentūra, Všį